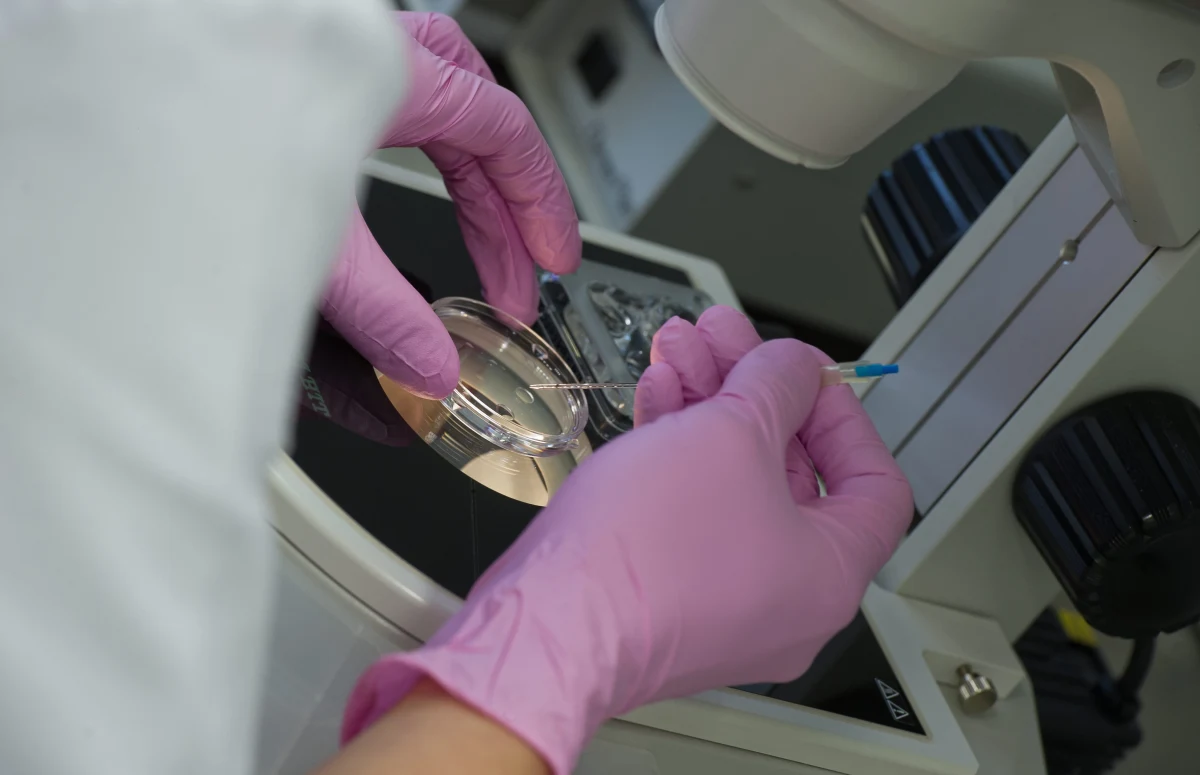
Do końca miesiąca mają się zakończyć przesłuchania lekarzy w sprawie pomyłki przy zapłodnieniu in vitro w klinice w Policach w Zachodniopomorskiem. Jak informuje nasza reporterka Aneta Łuczkowska, prokurator na początku sierpnia powoła biegłego, który oceni, czy zamiana komórki jajowej miała wpływ na to, że dziecko urodziło się ciężko chore. Kierownik laboratorium stanie przed Sądem Lekarskim.
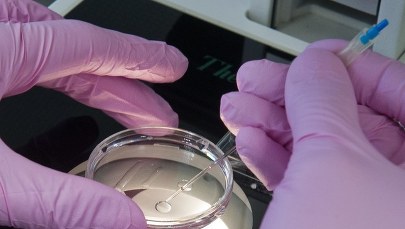
Ustawa o in vitro podpisana. Jeden punkt do TK

Do końca miesiąca mają się zakończyć przesłuchania lekarzy w sprawie pomyłki przy zapłodnieniu in vitro w klinice w Policach w Zachodniopomorskiem. Jak informuje nasza reporterka Aneta Łuczkowska, prokurator na początku sierpnia powoła biegłego, który oceni, czy zamiana komórki jajowej miała wpływ na to, że dziecko urodziło się ciężko chore. Kierownik laboratorium stanie przed Sądem Lekarskim.
Sprawa błędu przy zapłodnieniu in vitro się głośna na początku lutego, kiedy poinformował o niej "Głos Szczeciński". 30-letnia kobieta i jej mąż poddali się w zeszłym roku zabiegowi pozaustrojowego zapłodnienia w Laboratorium Wspomaganego Rozrodu w szpitalu w Policach. Kobieta zaszła w ciążę i urodziła córkę, która miała liczne wady wrodzone. Przeprowadzone badania DNA wykazały, że dziewczynka nie jest biologicznym dzieckiem 30-latki.
(mn)